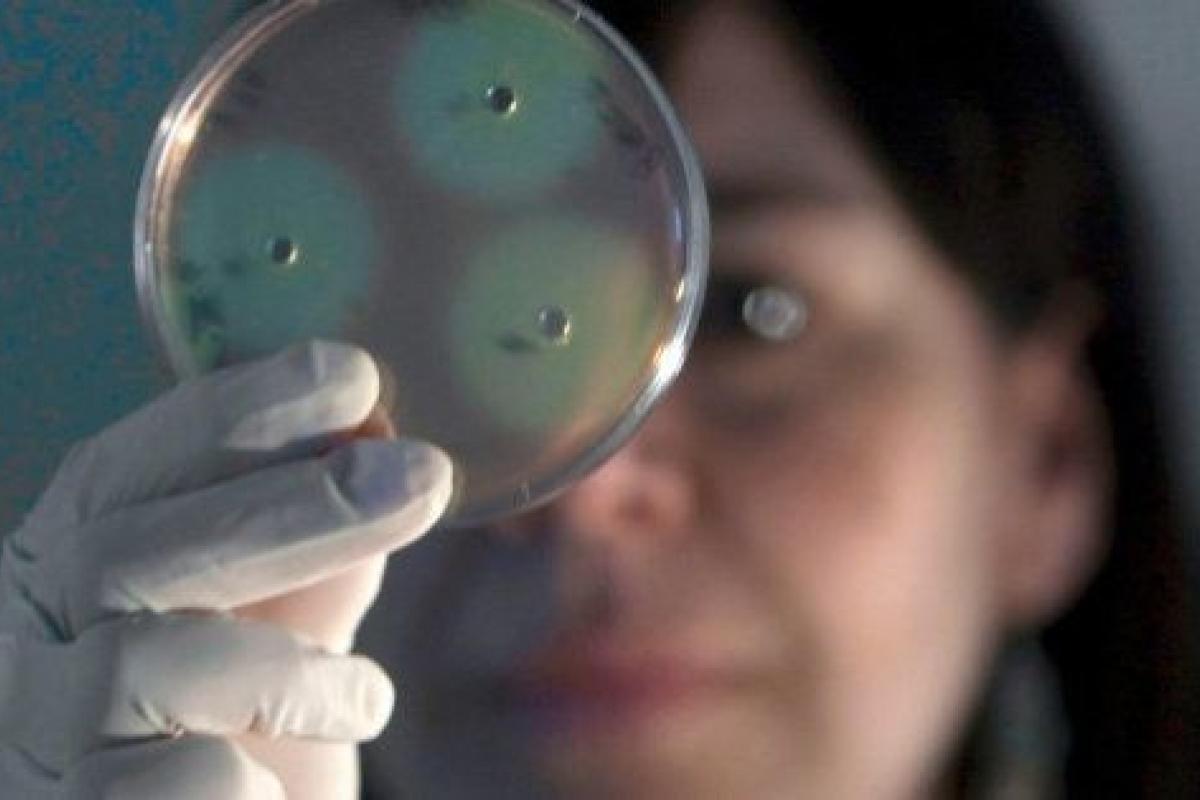

No dejes de ayudar. 11 ejemplos de que la implicación social es clave para la investigación
Una niña aquejada de una enfermedad rara, de nombre complicado: tricotiodistrofia. Un padre desesperado por mejorar la vida de su hija. Una petición de ayuda a la sociedad a través de los medios de comunicación. Y la respuesta de la gente, que donó su dinero para ayudar a la pequeña, sin saber que su padre, al parecer, gastó los 600.000 euros recaudados en cosas que nada tenían que ver con tratamiento o investigación para la dolencia de su hija.
Hasta el último giro de los acontecimientos, la campaña por Nadia era exactamente igual a las decenas de campañas que se lanzan cada año en España: un caso concreto como ejemplo de una dolencia, rara o no, casi siempre grave, siempre dura; el llamamiento de los familiares, la emoción y la respuesta económica de quienes se sienten afectados por la historia.
Es por eso que el impacto del caso va mucho más allá de la investigación y el encarcelamiento del padre, ahora bajo sospecha. Todo lo ocurrido en un proceso que ha durado varios años presenta elementos para dañar gravemente la confianza de todos en llamamientos como el que se hizo con Nadia. Sin confianza, no hay donativos. Y sin donativos, muchos proyectos de investigación o mejora de las condiciones de vida de enfermos morirán antes de nacer.
RAZONES PARA CREER
Juan Carrión, presidente de la Federación Española de Enfermedades Raras (FEDER), confía en que no sea así: “Se trata de un caso aislado que de ninguna manera refleja la realidad de nuestro colectivo; por ello, entendemos que no debe repercutir en la confianza hacia el resto de entidades que dedican su esfuerzo cada día a luchar por nuestra causa”.
Pero la premura con la que su federación y otras asociaciones dedicadas a lo mismo han alzado la voz para dejar claro que el caso Nadia no tiene nada que ver con el día a día de muchas de ellas muestra de alguna manera también su preocupación porque el escándalo erosione la confianza y el compromiso de la sociedad, que tanto trabajo cuesta mantener.
Un compromiso que, en la mayoría de los casos, da lugar a éxitos concretos en la lucha contra la enfermedad o en la ayuda a los que la padecen. Estos son 11 ejemplos:
1. El test de Sangre Oculta en Heces (SOH)
En 2007, el doctor Antonio Castells llevó a cabo un proyecto para la detección precoz de cáncer colorrectal mediante un sencillo test no invasivo. Sus investigaciones demostraron que esta prueba era equivalente a la colonoscopia en la detección de la enfermedad. Es más barata y es eficaz, pero no sólo eso: permite evitar la aparición de la enfermedad.
La Asociación Española contra el Cáncer, que había financiado su investigación, y otras entidades, han peleado desde entonces para que el procedimiento esté incluido en la Cartera de Servicios Comunes del Sistema Nacional de Salud. En el País Vasco y en Valencia, la cobertura es del 100%; en Andalucía y Madrid, en cambio, sólo del 3%.
2. El maratón ‘Cada segundo es vida” de EiTB
En su decimoséptima edición, que acaba de terminar, ha recaudado 462.289 euros para la investigación sobre enfermedades neurodegenerativas. Se trata del cuarto maratón que más recaudación ha obtenido, después de los que se dedicaron a la investigación contra el cáncer, en 2006 y 2014 y contra el cáncer infantil, en 2015.
3. La detección precoz del VIH en niños africanos
Dos gotas de sangre seca en una tarjeta de un papel de filtro especial. Eso es lo que cree que hace falta para diagnosticar el VIH en niños menores de 18 meses este equipo del Hospital Ramón y Cajal de Madrid, dirigido por África Holguín.
Una vía para diagnosticar y curar a miles de niños africanos que, a día de hoy, mueren sin recibir medicinas por falta de diagnóstico. Una vía que se propuso en Precipita y que está siendo investigada gracias a los 18.895 euros aportados por personas anónimas.
4. El reto del cubo helado
¿Te acuerdas? Miles de vídeos, de famosos y desconocidos, echándose por encima un cubo de agua gélida y animándote a hacer lo mismo, para luchar contra una enfermedad llamada ELA. Fue en 2014 y la Esclerosis Lateral Amiotrófica, hasta entonces prácticamente una desconocida por los españoles, entró en sus conciencias.
El reto del cubo helado fue una campaña internacional, pero en España tuvo una incidencia enorme. La Asociación Española de Esclerosis Lateral Amiotrófica (AdELA) recaudó 376.000 euros durante aquellos días; un dinero que se ha dedicado a cosas tan mundanas, pero tan importantes, como comprar ayudas técnicas para los enfermos, como ascensores, instrumentos de comunicación o coches adaptados.
5. Un procedimiento contra el mioblastoma
El doctor Lucas Krauel se sentía frustrado cada vez que un niño con neuroblastoma, un tipo muy agresivo de tumor infantil, llegaba a su unidad en el Hospital Sant Joan de Déu. La mayoría de las veces eran casos incurables a los que sólo podía dar cuidados paliativos.
Pero supo que el doctor LaQuaglia en el hospital Memorial Sloan Kettering de Nueva York estaba llevando a cabo un nuevo procedimiento quirúrgico que mejoraba significativamente la supervivencia de los niños. Y se fue, con una beca financiada por la AECC, para aprender la técnica durante un año y aplicarla a su regreso.
6. El Centro Maktub
Un centro pionero para el transplante de médula ósea, instalado en el Hospital Niño Jesús de Madrid, por el que han pasado ya casi 150 niños y jóvenes para recibir tratamiento.
Debe su nombre a una película, cuya recaudación se dedicó íntegramente a financiar el proyecto. Fue dirigida por Paco Arango, presidente de la Fundación Aladina, que hizo con el centro su mayor inversión: 500.000 euros.
7. El videojuego Brainful Legends
O lo que es lo mismo, una aplicación para potenciar las habilidades cognitivas de pacientes con Síndrome de Down y mejorar así su autonomía y su integración. El proyecto, encabezado por Mara Dierssen, del Center for Genomic Regulation, ha recaudado casi 20.000 euros. Se destinarán al desarrollo de la demo del juego y a su distribución.
8. Objetivo: el mieloma múltiple
El doctor Jesús San Miguel comenzó en 2002 un proyecto para mejorar el tratamiento de los pacientes de mieloma múltiple. Identificó un nuevo protocolo terapéutico que cambió la lucha contra esta dolencia en todo el mundo: duplicó la supervivencia de los pacientes.
La AECC financió aquel estudio y financia también el que el doctor está llevando a cabo ahora, para entender la resistencia del mieloma en un 30% de los casos y definir una segunda línea de tratamiento en pacientes que recaen.
9. Terapias génicas contra las enfermedades raras infantiles
162 personas han colaborado ya con este proyecto de FEDER y Helpify para investigar terapias monogénicas que podrían ser útiles para el tratamiento de hasta 180 enfermedades raras infantiles.
10. Diagnóstico más fácil para la celiaquía
6.395 euros recaudó en Precipita este proyecto que ya está en marcha. El dinero les permitió adquirir reactivos para buscar nuevos marcadores de la enfermedad y llevar a cabo pruebas con 30 nuevos individuos.
El equipo del Hospital Clínico San Carlos trabaja ahora en el estudio de los resultados y en las búsqueda de marcadores solubles en suero para afrontar el diagnóstico en los pacientes más complejos.
11. Seguir la huella de los tumores cerebrales
Hasta ahora, la única forma de diagnosticar tumores cerebrales, incluidos los muy agresivos y recónditos glioblastomas, era una invasiva y arriesgada biopsia del tejido cerebral. Pero el doctor Joan Seoane está llevando a cabo una investigación pionera para demostrar que el líquido cefalorraquídeo es crucial para el pronóstico, el tratamiento y la monitorización de los tumores.
Es decir, que los médicos podrán, con sólo una punción lumbar, diagnosticar, pronosticar, monitorizar y diseñar el plan terapéutico para los tumores cerebrales.
LA IMPLICACIÓN CIVIL
En estos 11 casos tiene una presencia destacada la Asociación Española contra el Cáncer. Con varias décadas de trabajo a sus espaldas, es un gigante que tiene invertidos 34 millones de euros en casi dos centenares de proyectos de investigación. El 85% de esos fondos procede de la sociedad civil.
“Aquí salimos todos con las huchas a la calle el día señalado, por mucha vergüenza que nos dé, pero nosotros lo hacemos sólo un día; hay gente de la asociación que lo hace todos los días”, explica Marta Puyol, directora de investigaciones de la AECC. Ella, que conoce la ciencia desde dentro como investigadora, es la persona que se encarga de decidir a qué proyectos dedica la Asociación el dinero.
Y de monitorizar qué pasa con cada euro, por eficacia y por transparencia: “Para que se entienda de manera gráfica, vigilamos que el dinero para 20 ratones se haya empleado en esos 20 ratones y que no se paguen 60 ratones cuando solo hacen falta 20”. Es decir: para que la AECC sepa qué ha pasado con los fondos, pero para que lo sepa también el ciudadano que ha echado su moneda en la hucha o ha realizado un donativo.
EXIGIR INFORMACIÓN Y GARANTÍAS
Puyol resalta que los protocolos de calidad y la trazabilidad son clave: “Hacemos convocatorias públicas, nos sometemos a un auditor externo que es la Agencia Nacional de Evaluación y Prospectiva y buscamos la calidad de los proyectos”. Es la manera más eficaz de conseguir avances, pero también de ser transparentes con una sociedad que se vuelca especialmente en estas causas:
“La sociedad española es solidaria y se vuelca mucho con estos casos. Además, ahora es muy consciente del recorte brutal que ha habido en investigación en el terreno de lo público, por lo que siente que tiene que contribuir con algo”, señala Puyol.
Esas dos cosas, la predisposición de las personas a ayudar y la conciencia de los recortes explica también el surgimiento de plataformas colaborativas como Precipita o Helpify, sitios para el crowdfunding y el crowsourcing de proyectos científicos, con transparencia, con la seguridad de equipos de científicos consolidados, trabajando en instituciones acreditadas. Algunos de ellos aparecen citados en la lista de ejemplos de un poco más arriba.
Todos tienen en común que plantean unos objetivos claros y cuentan qué hacen con el dinero, cuáles son los resultados, incluso cuáles son los fracasos. En ciencia, dado que los resultados no se pueden anticipar, cabe al menos exigir la transparencia.



